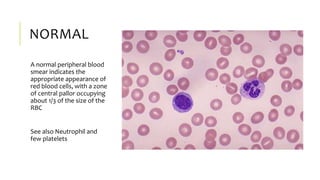
NORMAL
A normal peripheral blood
smear indicates the
appropriate appearance of
red blood cells, with a zone
of central pallor occupying
about 1/3 of the size of the
RBC
See also Neutrophil and
few platelets

This document provides information on anaemia, including its definition, epidemiology, pathophysiology, clinical features, investigations, classification, and management. It begins by defining anaemia as a decreased red blood cell mass that can be detected by low haemoglobin, haematocrit, and red blood cell count. Globally, anaemia prevalence is high in developing countries, especially among women and children in Africa. The pathophysiology involves inadequate red blood cell production due to iron deficiency, vitamin deficiencies, or chronic diseases. Common causes include iron deficiency, vitamin B12/folate deficiency, and anaemia of chronic disease. A complete blood count, peripheral smear, and targeted lab tests can help classify and diagnose the specific type of

![CLINICAL FEATURES
brittle hair, nail changes
[koilonychia (spoon-shaped)]
dysphagia
(e.g. oesophageal web, Plummer-Vinson ring)
pallor - conjunctiva, palmar creases
glossitis
angular stomatitis
(inflammation & fissuring at mouth corners)
pica
(appetite for non-food substances: ice, paint, dirt)](https://image.slidesharecdn.com/anaemias-bydrdele-180314181253/85/ANAEMIAS-by-Dr-DELE-48-320.jpg)









































